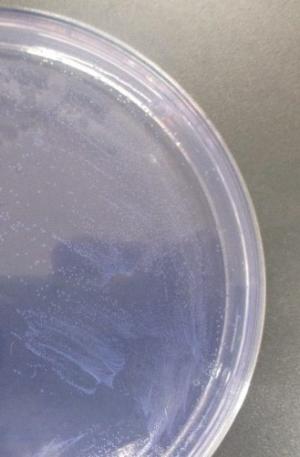
アザイド平板培地

本文
蕁麻疹型豚丹毒
と畜検査で認められた蕁麻疹型豚丹毒
豚丹毒は、豚丹毒菌(Erysipelothrix rhusiopathiae)を原因菌とする豚の細菌性疾患である。
急性型である敗血症型および蕁麻疹型、慢性型である関節炎型および心内膜炎型の四つの病型に分けられる。
届出伝染病に指定されており、人には類丹毒を起こす等人獣共通感染症としても重要である。
豚丹毒と診定された場合、全部廃棄措置の対象となる。
急性型である敗血症型および蕁麻疹型、慢性型である関節炎型および心内膜炎型の四つの病型に分けられる。
届出伝染病に指定されており、人には類丹毒を起こす等人獣共通感染症としても重要である。
豚丹毒と診定された場合、全部廃棄措置の対象となる。
剖検所見(枝肉検査)
皮膚に淡赤色~赤色で隆起した菱形の特徴的な病変(菱形疹)が認められる。

微生物検査による判定
増菌培養した後アザイド平板培地で分離を行う。
アザイド平板培地では、正円で露滴状の透明コロニーが認められる。
菌の形態はグラム陽性桿菌であり、しばしば独特なフィラメント状長連鎖を示す。
また、遺伝子検査を行う場合もある。
アザイド平板培地では、正円で露滴状の透明コロニーが認められる。
菌の形態はグラム陽性桿菌であり、しばしば独特なフィラメント状長連鎖を示す。
また、遺伝子検査を行う場合もある。